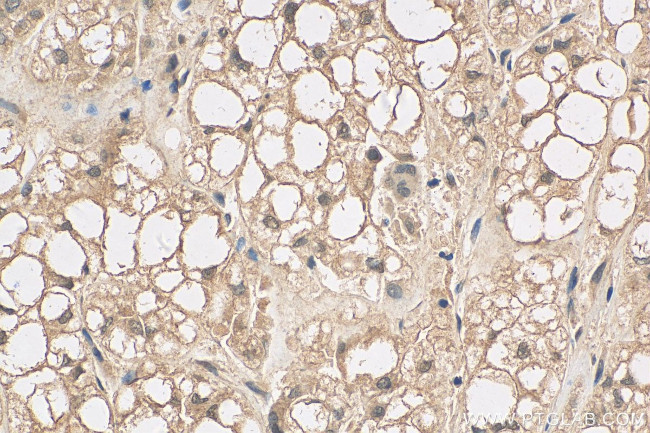
RAP1A Antibody in Immunohistochemistry (Paraffin) (IHC (P))

Search
Proteintech
RAP1A Monoclonal Antibody (1G12D8)
{{$productOrderCtrl.translations['antibody.pdp.commerceCard.promotion.promotions']}}
{{$productOrderCtrl.translations['antibody.pdp.commerceCard.promotion.viewpromo']}}
{{$productOrderCtrl.translations['antibody.pdp.commerceCard.promotion.promocode']}}: {{promo.promoCode}} {{promo.promoTitle}} {{promo.promoDescription}}. {{$productOrderCtrl.translations['antibody.pdp.commerceCard.promotion.learnmore']}}
产品信息
68125-1-IG150UL
种属反应
宿主/亚型
分类
类型
克隆号
偶联物
形式
浓度
纯化类型
保存液
内含物
保存条件
运输条件
靶标信息
The product of this gene belongs to the family of RAS-related proteins. These proteins share approximately 50% amino acid identity with the classical RAS proteins and have numerous structural features in common. The most striking difference between RAP proteins and RAS proteins resides in their 61st amino acid: glutamine in RAS is replaced by threonine in RAP proteins. The product of this gene counteracts the mitogenic function of RAS because it can interact with RAS GAPs and RAF in a competitive manner. Two transcript variants encoding the same protein have been identified for this gene.
仅用于科研。不用于诊断过程。未经明确授权不得转售。
篇参考文献 (0)
生物信息学
蛋白别名: C21KG; G-22K; GTP-binding protein smg p21A; GTP-binding protein SMG-P21A; RAS-related protein 1a; Ras-related protein Krev-1; Ras-related protein Rap-1A
基因别名: AI848598; C21KG; G-22K; KREV-1; KREV1; rap 1A; RAP-1A; RAP1; RAP1A; SMGP21
UniProt ID: (Human) P62834, (Mouse) P62835, (Rat) P62836
Entrez Gene ID: (Human) 5906, (Mouse) 109905, (Rat) 295347